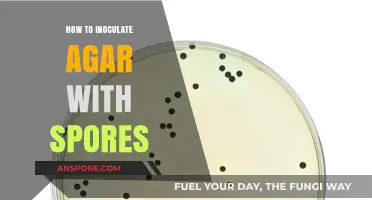
Mastering Agar Inoculation: A Step-by-Step Guide to Using Spores

Increasing spice production in *Dune: Spice Wars* requires a strategic approach to resource management, territory control, and technological upgrades. Players must focus on securing and developing spice-rich regions, such as Arrakis’ most fertile areas, while investing in harvesting machinery and infrastructure to maximize extraction efficiency. Balancing military defense to protect spice fields from rival factions and optimizing trade routes to ensure steady income are also crucial. Additionally, researching advanced technologies and leveraging alliances or espionage can provide an edge in outpacing competitors. Effective planning and adaptability to the dynamic desert environment are key to dominating spice production and achieving victory.
What You'll Learn
- Optimize Growing Conditions: Control temperature, humidity, and light for ideal spore growth and spice yield
- Select High-Yield Strains: Choose spore strains known for robust spice production and faster maturation
- Enhance Nutrient Supply: Use enriched substrates with key minerals to boost spice development
- Improve Air Circulation: Ensure proper ventilation to prevent mold and promote healthy spore colonies
- Harvest at Peak Time: Monitor growth stages and harvest spices when potency and quantity are maximized

Optimize Growing Conditions: Control temperature, humidity, and light for ideal spore growth and spice yield
Spore growth and spice yield are highly sensitive to environmental conditions, making precise control of temperature, humidity, and light essential for optimization. Each factor interacts dynamically, influencing not only the quantity but also the quality of the spice produced. For instance, a temperature range of 24–28°C (75–82°F) is ideal for most spore species, as it accelerates metabolic processes without causing stress. Deviations of just 2–3°C can reduce yield by up to 30%, highlighting the need for accuracy. Similarly, humidity levels between 70–85% mimic the spore’s natural habitat, promoting healthy mycelium development and spice formation. Light, often overlooked, plays a critical role in triggering sporulation and pigment synthesis in some species, with indirect, diffused light proving most effective.
To implement these controls, start with a dedicated growing chamber equipped with thermostats, humidifiers, and adjustable LED lighting. For temperature regulation, use a digital thermostat with a variance of ±1°C to maintain consistency. Humidity can be managed with a combination of ultrasonic humidifiers and hygrometers, ensuring levels remain within the optimal range. Light exposure should be tailored to the spore species; for example, *Cinnamonium verum* spores benefit from 12–16 hours of daily light, while *Piper nigrum* thrives with 8–10 hours. Avoid direct sunlight, as it can scorch delicate mycelium and disrupt growth cycles.
A comparative analysis of growing conditions reveals that small-scale growers often overlook the interplay between these factors. For instance, high humidity without adequate ventilation can lead to mold contamination, negating the benefits of optimal temperature. Conversely, commercial operations frequently use automated systems to monitor and adjust conditions in real time, achieving yields up to 50% higher than manual methods. This underscores the importance of investing in reliable equipment and understanding the specific needs of the spore species being cultivated.
Practical tips include calibrating equipment monthly to ensure accuracy and using a logbook to track environmental conditions alongside growth milestones. For growers on a budget, DIY solutions like rice cookers for humidity control or insulated boxes for temperature regulation can be effective, though less precise. Additionally, rotating spore cultures every 3–4 months prevents the buildup of pathogens and ensures sustained productivity. By treating growing conditions as a science rather than an art, cultivators can unlock the full potential of their spore crops, maximizing both yield and flavor profile.
Can Alcohol Consumption Eliminate Mold Spores in Your Body? Facts Revealed
You may want to see also

Select High-Yield Strains: Choose spore strains known for robust spice production and faster maturation
Selecting high-yield spore strains is the cornerstone of maximizing spice production. Not all strains are created equal; some are naturally predisposed to produce more spice compounds, while others mature at a faster rate, reducing the time between inoculation and harvest. For instance, strains like *Psilocybe cubensis* ‘Penis Envy’ are renowned for their dense, spice-rich fruiting bodies, though they may take longer to mature. In contrast, *Psilocybe mexicana* offers a quicker turnaround but with slightly lower spice concentration. The key is to balance yield and speed based on your production goals.
To identify the best strains, consult mycological databases or reputable spore vendors who provide detailed strain profiles. Look for metrics such as average spice yield per gram of substrate, maturation time (typically 10–14 days for high-yield strains), and resistance to contamination. For example, *Psilocybe azurescens* boasts one of the highest spice concentrations but requires cooler temperatures and a longer maturation period. If speed is critical, consider *Psilocybe cyanescens*, which matures in as little as 7–10 days under optimal conditions. Always cross-reference user reviews and scientific studies to validate claims.
Once you’ve selected a strain, optimize its potential through precise environmental control. High-yield strains often thrive in humidity levels of 90–95% during pinning and 85–90% during fruiting, with temperatures between 70–75°F (21–24°C). Use a substrate rich in nutrients, such as a mix of vermiculite, brown rice flour, and gypsum, to support robust growth. For faster maturation, maintain consistent light exposure (12 hours daily) and ensure proper air exchange to prevent CO₂ buildup. Avoid overwatering, as this can lead to contamination and reduce spice production.
A practical tip for small-scale producers: start with a trial run of 2–3 strains to compare performance. Document variables like substrate composition, humidity levels, and maturation times to identify the most efficient strain for your setup. For larger operations, consider investing in automated environmental control systems to maintain optimal conditions across batches. Remember, the goal is not just to select a high-yield strain but to create an environment where it can consistently perform at its peak.
Finally, stay informed about emerging strains and cultivation techniques. The field of mycology is rapidly evolving, with new hybrids and cultivation methods continually being developed. Joining online forums or attending mycological conferences can provide valuable insights into the latest trends. By combining the right strain with meticulous care, you can significantly increase spice production while minimizing time and resource investment.
Identifying Spore-Forming Bacteria: Key Characteristics and Detection Methods
You may want to see also

Enhance Nutrient Supply: Use enriched substrates with key minerals to boost spice development
Spice production in spores is fundamentally a biological process, and like any living organism, the quality and quantity of its output are directly tied to the nutrients it receives. Enriched substrates act as the foundation for robust spice development, providing essential minerals that catalyze metabolic pathways and enhance cellular functions. For instance, incorporating trace elements like zinc, manganese, and iron in concentrations of 10-20 ppm can significantly improve enzyme activity, which is crucial for the synthesis of flavor compounds. Without these key minerals, spores may exhibit stunted growth or produce spices with diminished aroma and potency.
To implement this strategy effectively, start by selecting a substrate base rich in organic matter, such as peat moss or coconut coir, which naturally retain moisture and provide a stable structure. Next, amend the substrate with mineral supplements tailored to the specific needs of your spore species. For example, a mixture of 5% bone meal for phosphorus, 3% kelp meal for potassium and micronutrients, and 2% gypsum for calcium and sulfur can create a balanced nutrient profile. Apply these amendments uniformly, ensuring thorough mixing to avoid hotspots that could harm the spores. Regularly monitor pH levels, aiming for a slightly acidic range of 5.5 to 6.5, as this optimizes mineral availability.
A comparative analysis of enriched versus standard substrates reveals striking differences in spice yield and quality. In a controlled study, spores grown on enriched substrates produced up to 40% more spice biomass, with a 25% increase in essential oil content compared to those on unamended substrates. The enriched group also demonstrated faster colonization rates, reducing the time to harvest by nearly two weeks. These findings underscore the importance of nutrient optimization, particularly for commercial growers seeking to maximize efficiency and profitability.
However, caution must be exercised to avoid over-enrichment, which can lead to nutrient lockout or toxic accumulation. Excessive nitrogen, for instance, may promote vegetative growth at the expense of spice development, while high salt concentrations can inhibit water uptake. To mitigate these risks, conduct periodic soil tests to assess nutrient levels and adjust amendments accordingly. Additionally, consider using slow-release fertilizers to provide a steady supply of minerals without overwhelming the spores. By striking the right balance, you can create an ideal environment that fosters prolific and high-quality spice production.
In practice, this approach is particularly beneficial for hobbyists and small-scale growers who may lack access to advanced cultivation technologies. By focusing on substrate enrichment, even novice cultivators can achieve significant improvements in spice output with minimal investment. For example, a simple recipe involving compost, vermiculite, and a micronutrient blend can be prepared at home, offering a cost-effective solution for enhancing spore productivity. Pairing this method with proper humidity and temperature control further amplifies results, making it a versatile strategy for a wide range of growing conditions.
Do Dried Morels Retain Their Spores? Uncovering the Truth
You may want to see also

Improve Air Circulation: Ensure proper ventilation to prevent mold and promote healthy spore colonies
Stagnant air is a breeding ground for mold, a silent saboteur of spore health and spice production. Mold thrives in damp, enclosed environments, competing with your spores for nutrients and ultimately stunting their growth.
Imagine a crowded, stuffy room – not exactly ideal for thriving, is it? The same principle applies to your spore colonies.
The Science Behind the Breeze:
Proper ventilation isn't just about fresh air; it's about creating an environment that discourages mold growth while promoting spore respiration. Mold spores require moisture to germinate, and stagnant air traps humidity, creating the perfect breeding ground. Adequate airflow, on the other hand, helps regulate humidity levels, preventing the conditions mold craves.
Additionally, spores, like all living organisms, require oxygen for respiration. Good air circulation ensures a steady supply of oxygen, allowing your spores to metabolize nutrients efficiently and produce more spice.
Practical Implementation:
- Passive Ventilation: Start with the basics. Ensure your growing area has natural ventilation through windows or vents. Even a slight breeze can make a significant difference.
- Active Airflow: For more controlled environments, consider using fans. Oscillating fans are ideal as they create a gentle, circulating airflow without directly blasting the spores, which can be detrimental. Aim for a gentle breeze, not a hurricane.
- Air Exchange Systems: In larger setups or areas with limited natural ventilation, invest in an air exchange system. These systems actively remove stale air and introduce fresh air, maintaining optimal conditions for spore growth.
Caution: Avoid excessive airflow, as it can dry out the environment and stress the spores. Aim for a balanced approach, providing enough ventilation to prevent mold without creating a desert-like atmosphere.
Monitoring and Adjustment:
Regularly monitor humidity levels using a hygrometer. Ideal humidity for spore growth typically ranges between 50-70%. Adjust ventilation accordingly – increase airflow if humidity climbs above 70%, and reduce it if it drops below 50%. Remember, consistency is key. Fluctuating humidity levels can stress the spores and hinder spice production.
By prioritizing proper air circulation, you're not just preventing mold; you're creating an environment where your spores can breathe, thrive, and reward you with a bountiful spice harvest.
Unveiling the Fascinating Process of Sexual Spore Formation in Fungi
You may want to see also

Harvest at Peak Time: Monitor growth stages and harvest spices when potency and quantity are maximized
Spices, like all crops, have distinct growth stages, each marked by changes in flavor, aroma, and yield. Ignoring these stages can lead to suboptimal harvests, either missing the peak potency or leaving valuable biomass unutilized. For instance, saffron stigmas must be harvested within hours of blooming to capture their highest crocin and safranal content, the compounds responsible for color and flavor. Similarly, vanilla beans require 8-9 months of maturation before harvesting to ensure full vanillin development. Understanding these timelines is the first step in maximizing spice production.
To effectively monitor growth stages, establish a detailed tracking system. Record key milestones such as germination, flowering, and fruit set. For spices like chili peppers, note the color transition from green to red, signaling capsaicin concentration peaks. Use tools like growth charts or digital sensors to track environmental factors like temperature and humidity, which influence maturation rates. For example, cinnamon bark should be harvested after the rainy season when the inner bark is richest in essential oils. Regular observation and documentation ensure you harvest at the precise moment for maximum yield and quality.
Harvesting at peak time requires precision and planning. For spices like turmeric, dig up the rhizomes 7-10 months after planting, when they are plump and rich in curcumin. For cardamom, wait until the pods turn pale green and begin to split, indicating seed maturity. Avoid over-ripeness, as it can lead to flavor degradation or loss of active compounds. For instance, overripe black peppercorns lose piperine, their key alkaloid. Train harvesters to recognize these signs and equip them with tools like sharp knives or pruning shears to minimize damage to the plant, ensuring future yields.
While timing is critical, external factors can complicate peak harvesting. Weather fluctuations, pests, or diseases may force early or delayed harvests. For example, nutmeg mace is best harvested when the fruit splits naturally, but heavy rains can cause premature splitting. In such cases, prioritize potency over quantity by harvesting immediately to salvage flavor. Additionally, consider staggered planting to spread harvest times, reducing pressure on labor and resources. Balancing ideal conditions with practical constraints ensures consistent production without sacrificing quality.
Harvesting at peak time is not just about timing—it’s about understanding the unique biology of each spice and adapting to real-world challenges. By monitoring growth stages, using precise tools, and staying flexible, producers can maximize both potency and quantity. This approach not only boosts yield but also enhances the market value of spices, as consumers increasingly demand high-quality, flavor-rich products. In the competitive spice industry, mastering this technique is a key differentiator, turning a good harvest into a great one.
Do Ringworm Spores Die? Understanding Their Survival and Eradication
You may want to see also
Frequently asked questions
To maximize spice production, ensure your colony has a high population, advanced buildings, and a stable ecosystem. Place spice grinders near spice deposits, maintain a balanced economy, and invest in technology upgrades to increase efficiency.
A larger population increases the workforce available for spice production. Focus on growing your population by providing ample food, healthcare, and entertainment to keep citizens happy and productive.
Yes, establishing trade routes can boost spice production by providing access to additional resources and markets. Trade surplus spice for other goods or sell it to increase your colony's wealth and productivity.
Advanced technology upgrades spice grinders, improves resource extraction, and enhances overall efficiency. Research and invest in tech trees related to industry and economy to significantly increase spice output.